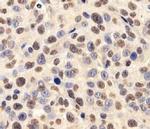
FUS Antibody in Immunohistochemistry (IHC)

Search
Invitrogen
FUS Polyclonal Antibody
{{$productOrderCtrl.translations['antibody.pdp.commerceCard.promotion.promotions']}}
{{$productOrderCtrl.translations['antibody.pdp.commerceCard.promotion.viewpromo']}}
{{$productOrderCtrl.translations['antibody.pdp.commerceCard.promotion.promocode']}}: {{promo.promoCode}} {{promo.promoTitle}} {{promo.promoDescription}}. {{$productOrderCtrl.translations['antibody.pdp.commerceCard.promotion.learnmore']}}
产品信息
PA5-23073
宿主/亚型
分类
类型
抗原
偶联物
形式
浓度
规格
保存条件
运输条件
RRID
产品详细信息
The target sequence has 95% sequence homology with mouse and 91% sequence homology with bovine.
靶标信息
This gene encodes a multifunctional protein component of the heterogeneous nuclear ribonucleoprotein (hnRNP) complex. The hnRNP complex is involved in pre-mRNA splicing and the export of fully processed mRNA to the cytoplasm. This protein belongs to the FET family of RNA-binding proteins which have been implicated in cellular processes that include regulation of gene expression, maintenance of genomic integrity and mRNA/microRNA processing. Alternative splicing results in multiple transcript variants. Defects in this gene result in amyotrophic lateral sclerosis type 6.
仅用于科研。不用于诊断过程。未经明确授权不得转售。